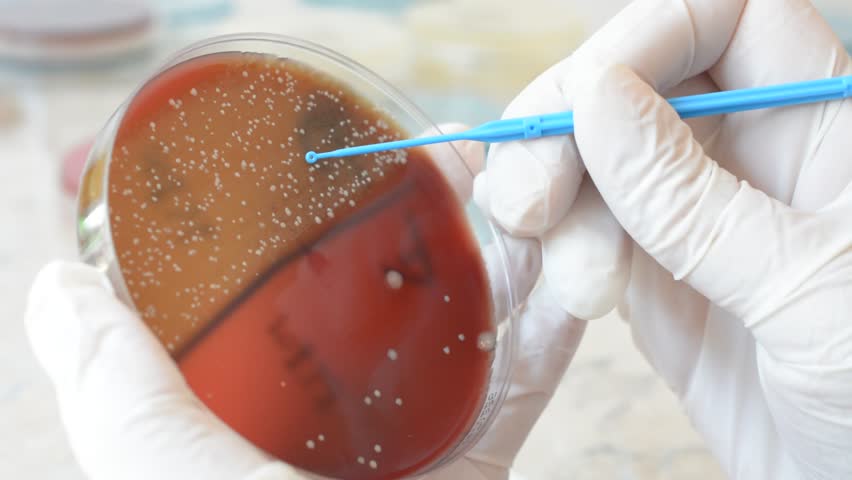

E coli тест
А ю ратнер
Ricoh 3055
Музыка дт
Делюкс ослепительно белая
Реган перевод
Обострение отношений с абхазией
Классификация стеноза артерий
Животные из красной книги песец
Темно серый цвет rgb
Синий трактор 2 песня
Poppy playtime бумага
Dangerous of sea
Первый актер дамблдора
E coli тест 117 фото